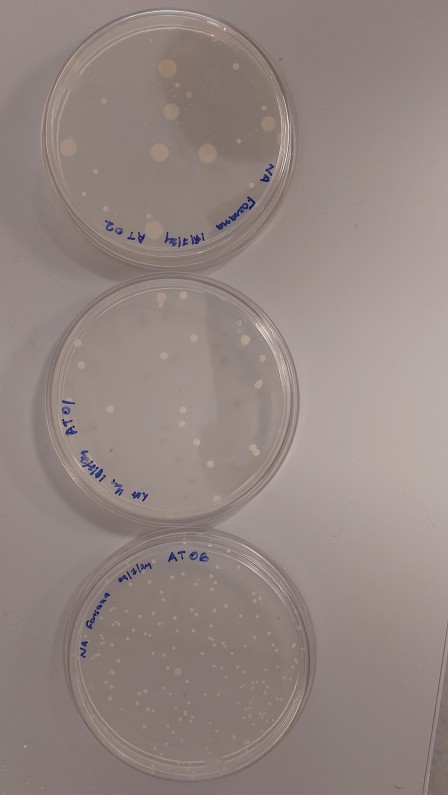

[home] [weblog] [science] [people] [station] [ny-ålesund] [sightings] [sitemap] [nederlands]

| [home] [weblog] [science] [people] [station] [ny-ålesund] [sightings] [sitemap] [nederlands] | more pages with this keyword at the end of this page  |
|
microbes in tern faeces |
22 July 2024 |
While checking tern nests, Susanne has been regularly covered in tern faeces. But Farsana from the Himadri Station was very interested in the faeces.
| |
| She incubated the faeces on agar plate and collected the colonies. | |
|

|
pages with keyword science
|
[home] [weblog] [science] [people] [station] [ny-ålesund] [sightings] [sitemap] [nederlands] | click on a picture for more information |
select a new keyword | |
| choose a keyword from the list in this box: | |
[360 video] [aquaria] [archaeology] [arctic fox] [arctic tern] [arcticexplorer.nl] [artist] [atmospheric research] [aurora borealis] [barnacle goose] [birdhealth] [catching] [cemetery] [common eider] [disease] [dogs] [eemshaven] [expedition] [faeces] [fish] [fjordcount] [geolocator] [geology] [geopolitics] [glaciers] [glaucous gull] [global warming] [gps-collar] [grouse] [guillemot] [history] [houses] [imprinting] [insects] [instructions] [kittiwake] [landscape] [limnology] [moult] [nest checking] [netherlands] [new species] [party] [people] [permafrost] [pink-footed goose] [plankton] [plants] [podcast] [polar bear] [pollution] [postmaster] [press] [publication] [reindeer] [ring reading] [rocket] [safety] [science] [seal] [skua] [snow] [snowbunting] [space research] [station] [streetview] [sustainability] [teaching] [tourism] [town] [unusual birds] [veterans] [video] [visitors] [waders] [whale] [wildlife camera] [young polar scientist] |